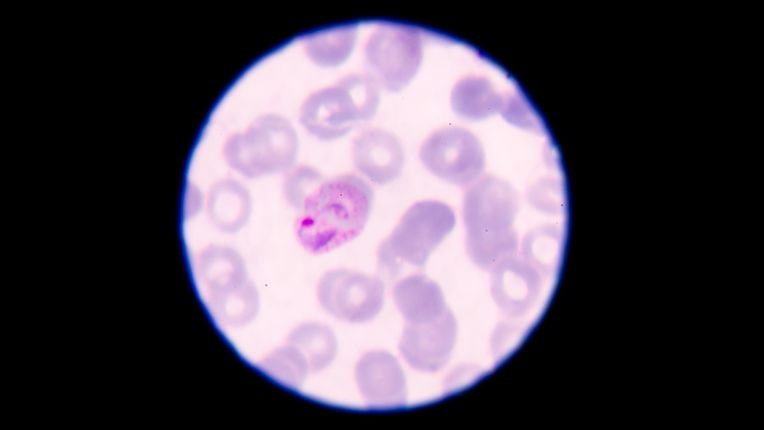
Centre de vaccination internationale (CVI) Toulouse. Image de l'agent du paludisme au milieu des cellules sanguines, au microscope.

Traitement préventif contre le paludisme à Nantes
Tableau récapitulatif sur le traitement préventif contre le paludisme à Nantes
🧭 Tableau récapitulatif : points pratiques sur le traitement préventif contre le paludisme à Nantes.
|
Centre de vaccination |
Centre de Vaccination Internationale Nantes Bellamy |
|---|---|
|
Adresse |
165 Rue Paul Bellamy, 44000 Nantes |
|
Accès |
Au fond de la place derrière le centre commercial |
|
Horaires d’ouverture |
lundi au samedi |
|
Prise de rendez-vous |
Par téléphone au XXX ou en ligne via Doctolib |
|
Accueil |
Avec ou sans rendez-vous |
|
Services |
Conseils donnés aux voyageurs sur la nécessité de prendre un traitement. Prescription si nécessaire. |
|
Public concerné |
Voyageurs se rendant dans des zones à risque en Afrique subsaharienne, Asie du Sud-Est, Amérique centrale et Amérique du Sud |
|
Prise en charge Sécurité sociale |
Non remboursé dans le cadre du centre de vaccination internationale de Nantes (sauf remboursement éventuel d'une complémentaire ou de l'employeur). |
A savoir sur le traitement contre le paludisme à Nantes
- Le paludisme est une maladie parasitaire transmise par les moustiques Anopheles.
- Cette infection est endémique dans de nombreux pays, notamment en Afrique tropicale et subsaharienne, ainsi qu’en Asie du Sud-Est et en Amérique latine.
- Pour les voyageurs, un traitement préventif peut être prescrit avant le départ.
- Une consultation au Centre de Vaccination Internationale ELSAN de Nantes Bellamy permet d’évaluer la nécessité de ce traitement.
- Une ordonnance est obligatoire et peut être délivrée au centre selon la situation.
- Deux vaccins existent, mais ils sont réservés aux jeunes enfants vivant dans les zones concernées.
Vaccin ou traitement contre le paludisme ?
-
Il n’existe pas de vaccin contre le paludisme destiné aux voyageurs. Les seuls vaccins disponibles concernent les enfants des pays touchés, dans le cadre des programmes de l’OMS.
-
La prévention repose sur un traitement médicamenteux prescrit avant le départ, associé à des mesures de protection contre les moustiques (moustiquaires, répulsifs, vêtements couvrants, etc.).
Où se faire prescrire un traitement contre le paludisme à Nantes ?
Vous habitez Nantes ou ses environs et souhaitez vous rendre dans des pays touchés par le paludisme, notamment :
- Afrique subsaharienne
- Asie du Sud-Est
- Amérique centrale
- Amérique du Sud
Pour obtenir un traitement préventif adapté, prenez rendez-vous au Centre de Vaccination Internationale Nantes Bellamy.
Centre de vaccination internationale Nantes Bellamy
Le Centre de Vaccination Internationale Nantes Bellamy est situé au 165 rue Paul Bellamy. Il est ouvert du lundi au samedi.
Notre équipe d’experts en médecine du voyage vous prodiguera des conseils personnalisés et vous accompagnera dans la mise à jour de vos vaccins obligatoires ainsi que de vos traitements préventifs pour vos voyages. Le centre vous accueille avec ou sans rendez-vous.
Qu'est ce que le paludisme ?
Maladie infectieuse tropicale
Le paludisme est une maladie parasitaire transmise par les moustiques anophèles. Les femelles, seules responsables des piqûres, sont actives principalement entre le coucher et le lever du soleil. Les voyageurs se rendant dans des zones impaludées doivent consulter afin d’évaluer la nécessité d’un traitement préventif. Ce traitement ne remplace pas la protection contre les moustiques sur place.
Adaptation au risque encouru
La chimioprophylaxie est prescrite en fonction du niveau de risque lié au séjour, notamment selon les régions visitées. Dans les zones de montagne, au sein de pays touché par le paludisme, le risque est très faible en raison des températures basses qui influencent le cycle du moustique et du parasite.
👉 Médicaments proposés
-
Atovaquone + proguanil,
-
Doxycycline,
-
Mefloquine
Ces traitements sont soumis à ordonnance.
Urgence
Si vous souffrez d'une fièvre au cours de votre voyage ou au retour de votre voyage à l'étranger, vous devez consulter immédiatement un ou une professionnelle de santé.
💡 Le Centre de Vaccination Internationale Nantes Bellamy fait partie des centres qui proposent la prophylaxie contre le paludisme.
Prévention contre le paludisme
La protection individuelle contre le moustique, vecteur de la maladie, est essentielle :
-
Porter des vêtements couvrants,
-
Utiliser des répulsifs,
-
Employer des insecticides,
-
Dormir sous moustiquaire,
⚠️ Important : la protection contre les moustiques et la prévention médicamenteuse sont complémentaires. Même sous prophylaxie, il est essentiel de continuer à se protéger, car les traitements ne garantissent pas une protection totale. À ce jour, aucun vaccin contre le paludisme n’est disponible pour les voyageurs.
Cartographie
L'Organisation mondiale de la santé (OMS) propose une carte des zones impaludées dans le monde.
Recommandations pour le traitement contre le paludisme
Médicaments contre le paludisme
Atovaquone-proguanil (Malarone®)
Le traitement le plus couramment prescrit est la combinaison d’atovaquone-proguanil (commercialisé sous le nom Malarone®). Il doit être commencé la veille du départ et poursuivi pendant sept jours après le retour.
Doxycycline (Vibramycine®, Vibra-Tabs®, Doxypalu®) et méfloquine (Lariam®)
La doxycycline doit être débutée la veille du départ et poursuivie pendant quatre semaines après avoir quitté la zone d’endémie. La méfloquine doit être commencée une à deux semaines avant le départ afin de vérifier sa tolérance. Elle se prend ensuite une fois par semaine pendant le séjour et pendant trois semaines après avoir quitté la zone impaludée.
Consultez un professionnel de santé formé à la médecine des voyages et à la vaccination à Nantes
👉 Avant de partir, prenez rendez-vous dans une consultation spécialisée pour déterminer la nécessité d’un traitement préventif contre le paludisme. Le personnel de notre Centre de Vaccination Internationale Nantes Bellamy vous fournira des conseils adaptés à votre situation et à votre destination. Respectez scrupuleusement les instructions de prise du médicament et consultez immédiatement en cas de symptômes ou d’alerte.
Recevez des conseils et un traitement contre le paludisme en une seule étape
👉 Au Centre de Vaccination Internationale Nantes Bellamy, vous pouvez obtenir à la fois des conseils personnalisés et, si nécessaire, une prescription lors d’un seul rendez-vous, pour préparer votre voyage en toute sérénité.
Sources
-
Elsan, mise à jour 23/12/2025
-
Assurance maladie, mise à jour 4/08/2025
-
Organisation mondiale de la santé (OMS), mise à jour 11/12/2024
-
Institut Pasteur, mise à jour 07/2024.
Cet article médical a été relu et validé par un médecin spécialiste en médecine générale au sein d’un établissement ELSAN, groupe leader de l’hospitalisation privée en France. Il a un but uniquement informatif et ne se substitue en aucun cas à l’avis de votre médecin, seul habilité à poser un diagnostic.
Pour établir un diagnostic médical précis et correspondant à votre cas personnel ou en savoir davantage et avoir plus d’informations sur votre pathologie, nous vous rappelons qu’il est indispensable de prendre contact et de consulter un médecin.
Vous trouverez ci-dessous, les médecins généralistes au sein des hôpitaux privés ELSAN, qui vous reçoivent en RDV près de chez vous, dans l’un de nos établissements.
Auteur
Article écrit le 29/12/2025Nx:, vérifié par Pierre Luton, etablissement
Questions fréquentes
Où faire un vaccin contre le paludisme à Nantes ?
Il n’existe pas de vaccin contre le paludisme destiné aux voyageurs. Un programme vaccinal existe néanmoins : les vaccins RTS,S/AS01 et R21/Matrix-M sont réservés aux enfants vivant dans les zones touchées, principalement en Afrique. Pour les voyageurs, une prévention médicamenteuse peut être proposée après consultation dans un Centre de Vaccination Internationale (CVI) ELSAN.
Vous pouvez obtenir un traitement préventif contre le paludisme au CVI Nantes Bellamy, situé au 165 rue Paul Bellamy à Nantes.
Combien de temps avant le départ faut-il faire le vaccin contre le paludisme ?
Dans la majorité des situations, le traitement peut être débuté la veille du départ. Il s’agit d’un traitement prophylactique médicamenteux et non d’un vaccin. Les vaccins contre le paludisme actuellement disponibles sont exclusivement destinés aux enfants vivant dans des zones impaludées, notamment en Afrique.



